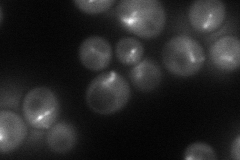
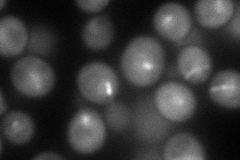

View description
Microtubule-associated protein, component of the interface between microtubules and kinetochore, involved in sister chromatid separation; essential in polyploid cells but not in haploid or diploid cells; ortholog of mammalian CLIP-170
Localization:
Intensity:
Fold change:
Significance:
-
C’ GFP library in SD

punctate24.93 -
N' NOP1pr-GFP in SD
punctate87.0776 -
N' TEF2pr-mCherry in SD
punctate120.126 -
N' NATIVEpr-GFP in SD

punctate18.2347 -
N' TEF2pr-VC and Cyto-VN in SD

#N/A0 -
C’ GFP library in SD+DTT

punctate22.530.9No -
C’ GFP library in SD+H2O2

punctate26.451.06No -
C’ GFP library in Starvation Media

punctate18.860.75Yes -
C’ GFP library on the background of Pup2-DaMP

punctate -
C’ GFP library on the background of CCT mutant

punctate26.72481.07143No
